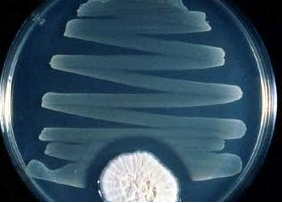

Les antibiotiques sauvent des vies
La moisissure n’est-elle pas mauvaise pour la santé et toxique? C’est vrai, mais pas seulement. En effet, les moisissures ont aussi des propriétés bénéfiques. En 1928, à son retour de vacances, le médecin écossais Alexander Fleming trouva dans son laboratoire londonien plusieurs boîtes de Petri qui n’avaient pas été nettoyées (cf. photo) et dans lesquelles il avait cultivé des bactéries avant ses vacances. Dans certaines de ces boîtes, une moisissure verdâtre appelée Penicillium s’était développée. Fleming fit alors une observation: autour des colonies de moisissures, il n’y avait pas de bactéries. Il en conclut que les moisissures avaient refoulé les bactéries. C’est cette observation accidentelle qui signe l’acte de naissance du premier antibiotique: la pénicilline.
© Christine Case
Mais son observation disparut dans les archives. Ce n’est que pendant la Seconde Guerre mondiale, lorsque l’armée eut besoin d’urgence d’un médicament contre les infections dont mouraient des milliers de soldats blessés, que les jeunes scientifiques britanniques Howard Walter Florey et Ernst Boris Chain se penchèrent en 1939 sur les travaux de Fleming et développèrent le premier médicament antibiotique. En 1945, Alexander Fleming fut lauréat, avec Florey et Chain, du prix Nobel de médecine. Pour la première fois dans l’histoire, les médecins n’étaient plus démunis face aux maladies dues à des bactéries comme par exemple la diphtérie, la scarlatine, la septicémie ou la pneumonie.

© wikipedia